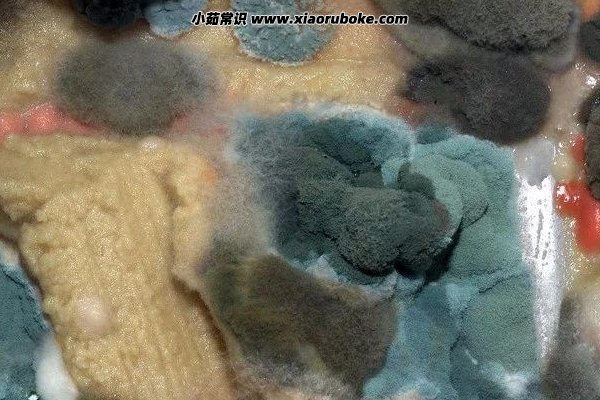

霉菌最怕三種東西((干燥/高溫/堿性環境(霉菌三大弱點)))
 xj
2023-07-08
xj
2023-07-08
網站小編空城舊憶據網絡最新關于“霉菌最怕三種東西((干燥/高溫/堿性環境(霉菌三大弱點)))”報道資料整理發布相關事件細節!
長期生活在潮濕溫潤的環境中,身邊的衣物很容易長上霉菌,這還不是最需要注意的,最需要注意的是自身的健康,一旦抵抗力下降,空里中的霉菌就會立馬影響到你,有關霉菌的疾病史最難治療的,所以一定要在源頭上斬斷霉菌的存在,霉菌最怕三種東西就是,干燥的環境、高溫環境、堿性環境。
霉菌最怕三種東西1、干燥

霉菌主要生存在比較溫潤潮濕的環境中,像比較干燥的環境中霉菌是生存不了的,所以想要消滅霉菌的話,可以在家中放置讓環境變干燥的產品,比如說干燥劑除濕袋等等,在家的話經常給室內經常通風,保持這個干燥的環境,霉菌就不會找上門來。
2、高溫環境
除了干燥之外霉菌最害怕的就是高溫環境,像衣物上生長霉菌的季節,一般都是每年的梅雨季,這時候氣候比較寒冷,還會經常的下雨潮濕溫暖,霉菌在這種天氣下是最好繁衍的,高溫是殺死霉菌的一大特點,想要殺死自己衣物上的霉菌,記得一定要在太陽大的天氣晾曬衣物。
3、堿性環境

霉菌的最喜歡的生存環境是酸性環境,如果你自身患了霉菌性疾病的話,必要的時候除了以上兩點祛除霉菌的方法,還要去醫院看看,及時就醫讓醫生給你開含有堿性的藥物,一定要及時去看,霉菌性疾病的話非常容易反復。
以上就是網站小編空城舊憶據網絡最新關于“霉菌最怕三種東西((干燥/高溫/堿性環境(霉菌三大弱點)))”報道資料整理發布相關事件細節!轉載請注明來
來探秘,本文標題:霉菌最怕三種東西((干燥/高溫/堿性環境(霉菌三大弱點)))
本文地址:
/qiqubaike/36303.html
- 上一篇:
- 下一篇: 螨蟲咬了是什么樣子圖(皮膚起紅點并瘙癢)
- 熱門文章
- 隨機tag
-
周公解夢棺材(周公解夢棺材入坑) 姓名算名(姓名算命姻緣) 中國最時尚的風格(中國最時尚的風格是什么 娓(娓娓動聽的造句) 中國最漂亮秋天(中國最美秋色排行榜) 世界最大的碑林西安碑林 及時溝通(建立適合兩個人的關系) 不一(不一樣的美男子) 新義安十杰(新義安十杰還有誰活著) UFO飛走后留下地球沒有的『外星物體』! 2262年有兩個春節是真的嗎 豬屁登的恐怖真相 龍生九子的故事(中國神話故事大全100個 楊貴妃的下落有哪些 不能(釘釘沒有檢測權限看不到分屏) 韓文網名大全(韓文網名大全女孩) 鏡匣是什么意思(鏗鏘是什么意思) 全球十大污染城市中國有沒有占名額呢 來自于中國臺灣(1992年研發方便面) 網名繁體字(網名繁體字轉換) 中國最牛蔬菜商(中國最牛蔬菜商人是誰) 古代的名字和身份(古代名字用法) 一貫等于多少文(一貫文是多少人民幣) 千古一帝墓穴多次被遷移最后從一個垃圾場挖













